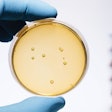
Chr. Hansen has one of the world’s largest commercial collections of bacteria strains, numbering more than 30,000.

Formerly a manufacturing engineer in the temperature-controlled biopharmaceutical industry, Keren Sookne took the helm of Healthcare Packaging in 2016, ensuring the most relevant trends and developments are covered in each issue. With in-depth process knowledge, she reports on materials science, automation, logistics/cold chain, traceability, and more for the highly regulated life science packaging community. Sookne holds a BS in chemical engineering from the University of California, Santa Barbara.